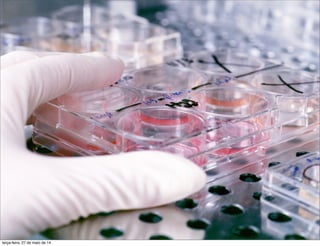
terça-feira, 27 de maio de 14

As startups diferem das grandes empresas em alguns aspectos fundamentais como não conhecer seus clientes, não ter uma marca estabelecida e não saber como vender. Startups podem crescer rapidamente mas planejam-se para períodos mais curtos, ao contrário das grandes empresas. O documento também discute a aplicação do método científico para testar hipóteses sobre problemas enfrentados por pequenas empresas.